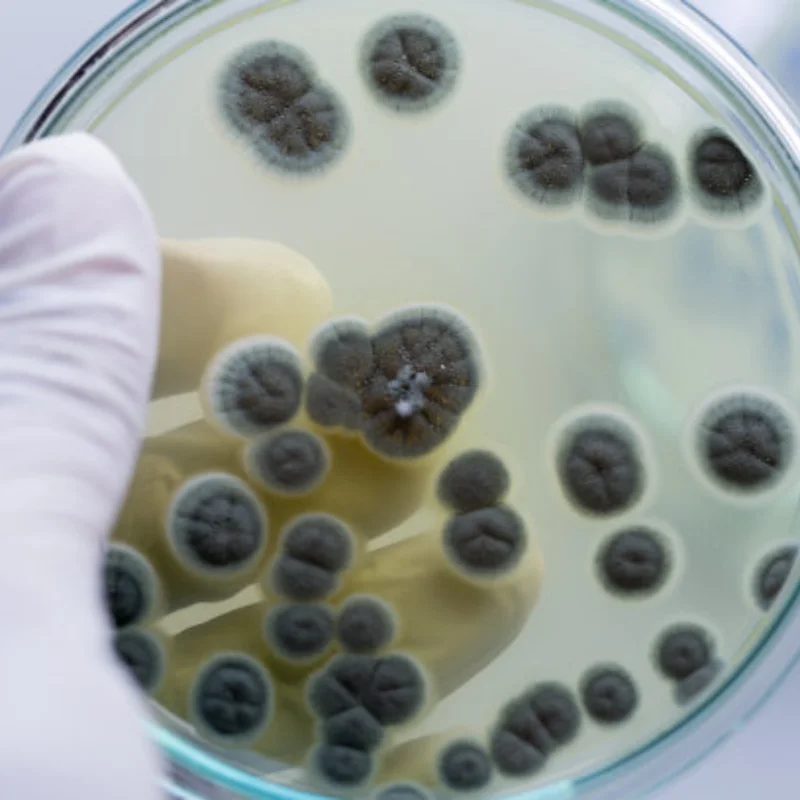
ยางรถแข่ง 4 ชิ้น พร้อมล้อแม็กซ์โลหะ 4 ชิ้น สำหรับรถ RC 1/10 แบบ On-Road รุ่น HSP 94123/94103/94122 D4/D3 FW06 WL144001 MJX16207

ยางรถแข่ง 4 ชิ้น พร้อมล้อแม็กซ์โลหะ 4 ชิ้น สำหรับรถ RC 1/10 แบบ On-Road รุ่น HSP 94123/94103/94122 D4/D3 FW06 WL144001 MJX16207
฿ 359.74
฿ 513.90
Save ฿ 154.16
-30%
IN STOCK
ราคาถูกและส่วนลด ยางรถแข่ง 4 ชิ้น พร้อมล้อแม็กซ์โลหะ 4 ชิ้น สำหรับรถ RC 1/10 แบบ On-Road รุ่น HSP 94123/94103/94122 D4/D3 FW06 WL144001 MJX16207 ขายส่ง ซื้อโดยตรงจาก Shop1103339363 Store
เพลิดเพลินกับสิทธิประโยชน์ดังต่อไปนี้:
🤑 บันทึก ฿ 154.16
📦 จัดส่งฟรีทั่วโลก
❤️คุณภาพสูง
🏠คืนง่าย
💰รับประกันคืนเงิน
ข้อมูลจำเพาะ
SKU:
ATS1005010392446413
เก็บ:
Shop1103339363 Store
หมวดหมู่:
ของเล่น&งานอดิเรก
หมวดหมู่ย่อย:
การควบคุมระยะไกล
การลดราคา:
-30%
บันทึกไว้:
฿ 154.16
ค่าจัดส่ง:
ของแถม